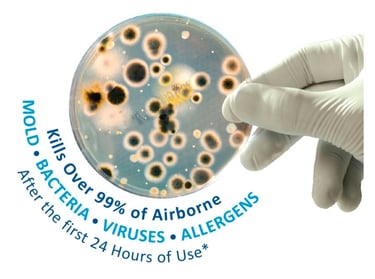
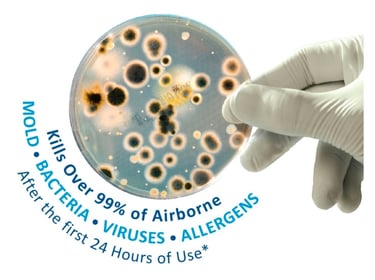

Experience Fresher Air in Your Home
The air we breathe inside our homes is often far worse than the air outside. Pollutants, mold, bacteria, and other contaminants can be present in indoor air at concentrations as much as five times higher than what you’ll find outdoors. These contaminants can have a negative impact on the comfort, health, and safety of those who are inside.
Indoor Air Quality Services
At COMFORT AC , we’re dedicated to enhancing your indoor air quality. Contact us at for solutions.
Combat Indoor Air Pollution with Expert Solutions
Indoor air quality has become a major concern for many households. This is due to the presence of airborne pollutants which can have a significant impact on both HVAC equipment and people’s health.
Common indoor air pollutants include:
Mold and bacteria
Pet dander and fur
Dust and dirt
Biological contaminants
Chemicals
Radon
Smoke
Viruses
Gases
Poor indoor air quality may lead to an increase in asthma symptoms or allergies, as well as cause respiratory problems including chest tightness and wheezing. In addition to this, it can also affect the efficiency of your heating and cooling systems by clogging filters with dirt and debris which makes them work harder than they need to. An experienced COMFORT AC expert will help you identify potential sources of pollution within your home so you can take steps toward improving your indoor air quality.
Air Scrubbers
At COMFORT AC , we highly recommend installing an Air Scrubber by Aerus with Certified Space Technology. If you want to protect your family, Air Scrubbers are scientifically proven to clean, deodorize, purify, and protect.
Here are some quick facts regarding this Air Scrubber:
Reduces indoor air quality risks known as Sick Building Syndrome
It attaches easily to your specific heating & cooling system
Uses proprietary light waves along with a specialized catalytic process to keep your home clean 24 hours a day and 7 days a week
Requires only 18 watts of electricity
Complies with all Federal EPA, FDA & OSHA regulators including the California Air Resource Boat Regulations
It has been proven effective in the International Space Station, Ground Zero Museum, Liberty Bell, Major League Baseball facilities, hospitals, schools, homes, and international hotel brands
CARB Certified (ozone free)
Technology is designed, engineered, and produced in the U.S.A.




HVAC UV LIGHT SYSTEMS




World’s Most popular HVAC UV Light
Blue-Tube UV is the single most popular germicidal UV light product for HVAC systems in the world. Home owners breathe easy knowing that the air their family breathes is protected by this proven technology. Blue-Tube UV is the simple, safe, and effective way to keep your air system clean and improve indoor air quality.
How Blue-Tube UV® Works
Blue-Tube UV is installed in the central air system where it works continuously to fight mold and other biological contaminants in the air and on HVAC system interior surfaces, particularly the cooling coil. For over a century scientists have known that certain frequencies of light have a devastating effect on microbial life. We now know that exposure to ultraviolet light in the range of 254 NM (UV-C band) disrupts the DNA of micro-organisms thus preventing them from reproducing, thereby effectively killing them.

Contact Comfort AC and Heating Today!
A member of our team will be in touch shortly to confirm your contact details or address questions you may have.


Address
2203 Pleasure rum dr Ruskin Fl 33570
Opening hours
Monday - Friday: 8:00 - 8:00
Saturday: 9:00 - 5:00
Sunday: 9:00 - 5:00
Contacts
bestcomfortac2020@gmail.com
941-402-0223
